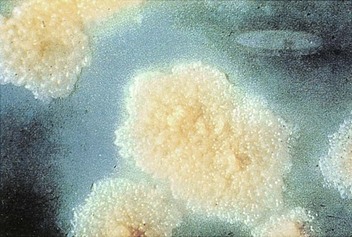
image

25 Mycobacterium
1. What important properties distinguish Mycobacterium from other genera of gram-positive rods?
2. Why is one third of the world population infected with M. tuberculosis?
3. What populations are at risk for infection with M. avium or M. fortuitum?
Answers
1. Mycobacteria have a cell wall rich in lipids that is responsible for many of the characteristic properties of the bacteria such as acid-fastness, slow growth, resistance to detergents, and resistance to common antibacterial antibiotics.
2. M. tuberculosis can establish chronic infections and persist in the infected individual for life. As immunity wanes in old age or through disease, the organism can become active, initiate replication, and produce disease. Because the organism is highly infectious, it can spread from person to person and become established in the entire community.
3. M. avium is an opportunistic pathogen, most commonly infecting immunocompromised patients but also individuals with chronic pulmonary disease, such as bronchiectasis. M. fortuitum and the other “rapidly growing” mycobacteria are opportunistic pathogens introduced into wounds or contaminating intravenous catheters.
The genus Mycobacterium (Table 25-1) consists of nonmotile, non–spore-forming, aerobic rods that are 0.2 to 0.6 × 1 to 10 µm in size. The rods occasionally form branched filaments, but these can be readily disrupted. The cell wall is rich in lipids, making the surface hydrophobic and the mycobacteria resistant to many disinfectants and common laboratory stains. Once stained, the rods also cannot be decolorized with acid solutions; hence the name acid-fast bacteria. Most mycobacteria divide slowly, and cultures require incubation for up to 8 weeks before growth is detected because the structure of the cell wall is complex and the organisms have fastidious growth requirements.
Table 25-1 Important Mycobacteria
| Organism | Historical Derivation |
|---|---|
| Mycobacterium | myces, a fungus; bakterion, a small rod (fungus-like rod) |
| M. abscessus | abscessus, of abscesses (causes abscess formation) |
| M. avium | avis, of birds (causes tuberculosis-like illness in birds) |
| M. chelonae | chelone, a tortoise (initial source) |
| M. fortuitum | fortuitum, casual, accidental (refers to fact this is an opportunistic pathogen) |
| M. haemophilum | haema, blood; philos, loving (blood loving; refers to requirement for blood or hemin for in vitro growth) |
| M. intracellulare | intra, within, cella, small room (within cells; refers to the intracellular location of this and all mycobacteria) |
| M. kansasii | kansasii, of Kansas (where the organism was originally isolated) |
| M. leprae | lepra, of leprosy (the cause of leprosy) |
| M. marinum | marinum, of the sea (bacterium associated with contaminated freshwater and saltwater) |
| M. tuberculosis | tuberculum, a small swelling or tubercle; osis (characterized by tubercles; refers to the formation of tubercles in the lungs of infected patients) |
Mycobacteria are a significant cause of morbidity and mortality, particularly in countries with limited medical resources. Currently, more than 150 species of mycobacteria have been described, many of which are associated with human disease (Table 25-2). Despite the abundance of mycobacterial species, the following few species or groups cause most human infections: M. tuberculosis, M. leprae, M. avium complex, M. kansasii, M. fortuitum, M. chelonae, and M. abscessus.
Table 25-2 Classification of Selected Mycobacteria Pathogenic for Humans
| Organism | Pathogenicity | Frequency in United States |
|---|---|---|
| Mycobacterium tuberculosis Complex | ||
| M. tuberculosis | Strictly pathogenic | Common |
| M. leprae | Strictly pathogenic | Uncommon |
| M. africanum | Strictly pathogenic | Rare |
| M. bovis | Strictly pathogenic | Rare |
| M. bovis BCG (bacille Calmette-Guérin strain) | Sometimes pathogenic | Rare |
| Slow-Growing Nontuberculous Mycobacteria | ||
| M. avium complex | Usually pathogenic | Common |
| M. kansasii | Usually pathogenic | Common |
| M. marinum | Usually pathogenic | Uncommon |
| M. simiae | Usually pathogenic | Uncommon |
| M. szulgai | Usually pathogenic | Uncommon |
| M. genavense | Usually pathogenic | Uncommon |
| M. haemophilum | Usually pathogenic | Uncommon |
| M. malmoense | Usually pathogenic | Uncommon |
| M. ulcerans | Usually pathogenic | Uncommon |
| M. scrofulaceum | Sometimes pathogenic | Uncommon |
| M. xenopi | Sometimes pathogenic | Uncommon |
| Rapidly Growing Nontuberculous Mycobacteria | ||
| M. abscessus | Sometimes pathogenic | Common |
| M. chelonae | Sometimes pathogenic | Common |
| M. fortuitum | Sometimes pathogenic | Common |
| M. mucogenicum | Sometimes pathogenic | Common |
Physiology and Structure of Mycobacteria
Bacteria are classified in the genus Mycobacterium on the basis of (1) their acid-fastness, (2) the presence of mycolic acids containing 70 to 90 carbons, and (3) a high (61% to 71 mol%) guanine plus cytosine (G+C) content in their deoxyribonucleic acid (DNA). Although other species of bacteria can be acid-fast (i.e., Nocardia, Rhodococcus, Tsukamurella, Gordonia), they stain less intensely (partially acid-fast) and their mycolic acids chains are shorter.
Mycobacteria possess a complex, lipid-rich cell wall (Figure 25-1). This cell wall is responsible for many of the characteristic properties of the bacteria (e.g., acid-fastness; slow growth; resistance to detergents, common antibacterial antibiotics, and the host immune response; antigenicity). The basic structure of the cell wall is typical of gram-positive bacteria: an inner plasma membrane overlaid with a thick peptidoglycan layer and no outer membrane. However, the mycobacterial cell wall structure is far more complex than that in other gram-positive bacteria. Anchored in the plasma membrane are proteins, phosphatidylinositol mannosides, and lipoarabinomannan (LAM). LAM is functionally related to the O-antigenic lipopolysaccharides present in other bacteria. Additional lipids, glycolipids, and peptidoglycolipids are also present. The lipid components comprise 60% of the cell wall weight. Transport proteins and porins are interspersed throughout the cell wall layers, and these constitute 15% of the cell wall weight. The proteins are biologically important antigens, stimulating the patient’s cellular immune response. Extracted and partially purified preparations of these protein derivatives (purified protein derivatives [PPDs]) are used as skin test reagents to measure exposure to M. tuberculosis. Similar preparations from other mycobacteria have been used as species-specific skin test reagents.

Figure 25-1 Mycobacterial cell wall structure. The components include the (A) plasma membrane, (B) peptidoglycans, (C) arabinogalactan, (D) mannose-capped lipoarabinomannan, (E) plasma-associated and cell wall–associated proteins, (F) mycolic acids, and (G) glycolipid surface molecules associated with the mycolic acids.
(Modified from Karakousis, et al: Mycobacterium tuberculosis cell wall lipids and the host immune response, Cell Microbiol 6:105–116, 2004.)
Growth properties and colonial morphology are used for the preliminary classification of mycobacteria. As noted earlier, M. tuberculosis and closely related species in the M. tuberculosis complex are slow-growing bacteria. The colonies of these mycobacteria are either nonpigmented or a light tan color (Figure 25-2). The other mycobacteria, now referred to as “nontuberculous mycobacteria” (NTM), were classified originally by Runyon by their rate of growth and pigmentation (see Table 25-2). The pigmented mycobacteria produce intensely yellow carotenoids, which may be stimulated by exposure to light (photochromogenic organisms Figure 25-3) or produced in the absence of light (scotochromogenic organisms). The Runyon classification scheme of NTM consists of four groups: slow-growing photochromogens (e.g., M. kansasii, M. marinum), slow-growing scotochromogens (e.g., M. gordonae—a commonly isolated nonpathogen), slow-growing nonpigmented mycobacteria (e.g., M. avium, M. intracellulare), and rapidly growing mycobacteria (e.g., M. fortuitum, M. chelonae, M. abscessus). Currently used methods for the rapid detection and identification of mycobacteria have made this scheme less important. Nonetheless, a pigmented or a rapidly growing Mycobacterium should never be mistaken for M. tuberculosis.
Mycobacterium tuberculosis (Box 25-1)
Pathogenesis and Immunity
M. tuberculosis is an intracellular pathogen that is able to establish lifelong infection. At the time of exposure, M. tuberculosis enters the respiratory airways and infectious particles penetrate to the alveoli where they are phagocytized by alveolar macrophages. In contrast with most phagocytized bacteria, M. tuberculosis prevents fusion of the phagosome with lysosomes (by blocking the specific bridging molecule, early endosomal autoantigen 1 [EEA1]). At the same time, the phagosome is able to fuse with other intracellular vesicles, permitting access to nutrients and facilitating intravacuole replication. Phagocytized bacteria are also able to evade macrophage killing mediated by reactive nitrogen intermediates formed between nitric oxide and superoxide anions by catalytically catabolizing the oxidants that are formed.
Box 25-1 Summary
Mycobacterium tuberculosis
Biology, Virulence, and Disease
Weakly gram-positive, strongly acid-fast, aerobic rods
Lipid-rich cell wall, making the organism resistant to disinfectants, detergents, common antibacterial antibiotics, host immune response, and traditional stains
Capable of intracellular growth in alveolar macrophages
Disease primarily from host response to infection
Primary infection is pulmonary
Dissemination to any body site occurs most commonly in immunocompromised patients
Epidemiology
Worldwide; one third of the world’s population is infected with this organism
A total of 9 million new cases each year and 2 million deaths
Disease most common in Southeast Asia, sub-Saharan Africa, and Eastern Europe
Just more than 11,000 new cases in United States in 2010
Populations at greatest risk for disease are immunocompromised patients (particularly those with HIV infection), drug or alcohol abusers, homeless persons, and individuals exposed to diseased patients
Diagnosis
Tuberculin skin test and interferon-γ release tests are sensitive markers for exposure to organism
Microscopy and culture are sensitive and specific
Direct detection by molecular probes is relatively insensitive except for acid-fast smear-positive specimens
Identification most commonly made using species-specific molecular probes
Treatment, Prevention, and Control
Prolonged treatment with multiple drugs is required to prevent development of drug-resistant strains
Isoniazid (INH), ethambutol, pyrazinamide, and rifampin for 2 months followed by 4 to 6 months of INH and rifampin or alternative combination drugs
Prophylaxis for exposure to tuberculosis can include INH for 6 to 9 months or rifampin for 4 months; pyrazinamide and ethambutol or levofloxacin are used for 6 to 12 months after exposure to drug-resistant M. tuberculosis
Immunoprophylaxis with bacille Calmette-Guérin in endemic countries
Control of disease through active surveillance, prophylactic and therapeutic intervention, and careful case monitoring
HIV, Human immunodeficiency virus; INH, isonicotinylhydrazine.
In response to infection with M. tuberculosis, macrophages secrete interleukin-12 (IL-12) and tumor necrosis factor-α (TNF-α). These cytokines increase localized inflammation with the recruitment of T cells and natural killer (NK) cells into the area of the infected macrophages, inducing T-cell differentiation into TH1 cells (T-helper cells), with subsequent secretion of interferon-γ (IFN-γ). In the presence of IFN-γ, the infected macrophages are activated, leading to increased phagosome-lysosome fusion and intracellular killing. In addition, TNF-α stimulates production of nitric oxide and related reactive nitrogen intermediates, leading to enhanced intracellular killing. Patients with decreased production of IFN-γ or TNF-α, or who have defects in the receptors for these cytokines, are at increased risk for severe mycobacterial infections.
The effectiveness of bacterial elimination is in part related to the size of the focus of infection. Alveolar macrophages, epithelioid cells, and Langhans giant cells (fused epithelioid cells) with intracellular mycobacteria form the central core of a necrotic mass that is surrounded by a dense wall of macrophages and CD4, CD8, and NK T cells. This structure, a granuloma, prevents further spread of the bacteria. If a small antigenic burden is present at the time the macrophages are stimulated, the granuloma is small and the bacteria are destroyed with minimal tissue damage; however, if many bacteria are present, the large necrotic or caseous granulomas become encapsulated with fibrin that effectively protects the bacteria from macrophage killing. The bacteria can remain dormant in this stage or can be reactivated years later when the patient’s immunologic responsiveness wanes as the result of old age or immunosuppressive disease or therapy. This process is the reason that disease may not develop until late in life in patients exposed to M. tuberculosis.
Epidemiology
Although tuberculosis can be established in primates and laboratory animals, such as guinea pigs, humans are the only natural reservoir. The disease is spread by close person-to-person contact through the inhalation of infectious aerosols. Large particles are trapped on mucosal surfaces and removed by the ciliary action of the respiratory tree. However, small particles containing one to three tubercle bacilli can reach the alveolar spaces and establish infection.
The World Health Organization (WHO) estimates that one third of the world’s population is infected with M. tuberculosis. Currently there are almost 9 million new cases and 2 million deaths caused by M. tuberculosis annually (that is, one death every 20 seconds). Regions with the highest incidence of disease are sub-Saharan Africa, Southeast Asia, and Eastern Europe. In the United States, the incidence of tuberculosis has decreased steadily since 1992 (Figure 25-4). In 2010, just more than 11,000 cases were reported, with almost 60% of the infections in foreign-born persons. Other populations at increased risk for M. tuberculosis disease are homeless persons, drug and alcohol abusers, prisoners, and people infected with the human immunodeficiency virus (HIV). Because it is difficult to eradicate disease in these patients, spread of the infection to other populations, including health care workers, poses a significant public health problem. This is particularly true for drug-resistant M. tuberculosis because patients who receive inadequate treatment may remain infectious for a long time.
Clinical Diseases (Clinical Case 25-1)
Although tuberculosis can involve any organ, most infections in immunocompetent patients are restricted to the lungs. The initial pulmonary focus is the middle or lower lung fields, where the tubercle bacilli can multiply freely. The patient’s cellular immunity is activated, and mycobacterial replication ceases in most patients within 3 to 6 weeks after exposure to the organism. Approximately 5% of patients exposed to M. tuberculosis progress to having active disease within 2 years, and another 5% to 10% experience disease sometime later in life.
Clinical Case 25-1
Drug-Resistant Mycobacterium tuberculosis
The risk of active tuberculosis is significantly increased in HIV-infected individuals. Unfortunately, this problem is complicated by the development of drug-resistant M. tuberculosis strains in this population. This was illustrated by the report by Gandhi and associates (Lancet 368:1575–1580, 2006) who studied the prevalence of tuberculosis in South Africa from January 2005 to March 2006. They identified 475 patients with culture-confirmed tuberculosis, of whom 39% had multidrug-resistant strains (MDR TB) and 6% with extensively drug-resistant strains (XDR TB). All patients with XDR TB were co-infected with HIV, and 98% of these patients died. The high prevalence of MDR TB and the evolution of XDR TB pose a serious challenge for tuberculosis treatment programs and emphasize the need for rapid diagnostic tests.
The likelihood that infection will progress to active disease is a function of both the infectious dose and the patient’s immune competence. For example, active disease develops within 1 year of exposure in approximately 10% of patients who are infected with HIV and have a low CD4 T-cell count, compared with a 10% risk of disease during the lifetime of patients without HIV infection. In patients with HIV infection, disease usually appears before the onset of other opportunistic infections, is twice as likely to spread to extrapulmonary sites, and can progress rapidly to death.
The clinical signs and symptoms of tuberculosis reflect the site of infection, with primary disease usually restricted to the lower respiratory tract. The disease is insidious at onset. Patients typically have nonspecific complaints of malaise, weight loss, cough, and night sweats. Sputum may be scant or bloody and purulent. Sputum production with hemoptysis is associated with tissue destruction (e.g., cavitary disease). The clinical diagnosis is supported by (1) radiographic evidence of pulmonary disease (Figure 25-5), (2) positive skin test reactivity, and (3) the laboratory detection of mycobacteria, either with microscopy or in cultures. One or both upper lobes of the lungs are usually involved in patients with active disease that includes pneumonitis or abscess formation and cavitation.
Extrapulmonary tuberculosis can occur as the result of the hematogenous spread of the bacilli during the initial phase of multiplication. There may be no evidence of pulmonary disease in patients with disseminated tuberculosis.
Mycobacterium leprae (Box 25-2)
Pathogenesis and Immunity
Leprosy (also called Hansen disease) is caused by M. leprae. Because the bacteria multiply very slowly, the incubation period is prolonged, with symptoms developing as long as 20 years after infection. As with M. tuberculosis infections, the clinical manifestations of leprosy depend on the patient’s immune reaction to the bacteria. The clinical presentation of leprosy ranges from the tuberculoid form to the lepromatous form. Patients with tuberculoid leprosy (also called paucibacillary Hansen disease) have a strong cellular immune reaction with many lymphocytes and granulomas present in the tissues and relatively few bacteria (Table 25-3). As in M. tuberculosis infections in immunocompetent patients, the bacteria induce cytokine production that mediates macrophage activation, phagocytosis, and bacillary clearance.
Box 25-2 Summary
Mycobacterium leprae
Epidemiology
Fewer than 300,000 new cases were reported in 2005, with most cases in India, Nepal, and Brazil
Approximately 100 new cases reported in United States annually
Lepromatous form of disease, but not the tuberculoid form, is highly infectious
Person-to-person spread by direct contact or inhalation of infectious aerosols
Table 25-3 Clinical and Immunologic Manifestations of Leprosy
| Features | Tuberculoid Leprosy | Lepromatous Leprosy |
|---|---|---|
| Skin lesions | Few erythematous or hypopigmented plaques with flat centers and raised, demarcated borders; peripheral nerve damage with complete sensory loss; visible enlargement of nerves | Many erythematous macules, papules, or nodules extensive tissue destruction (e.g., nasal cartilage, bones, ears); diffuse nerve involvement with patchy sensory loss; lack of nerve enlargement |
| Histopathology | Infiltration of lymphocytes around center of epithelial cells; presence of Langhans cells; few or no acid-fast rods observed | Predominantly “foamy” macrophages with few lymphocytes; lack of Langhans cells; numerous acid-fast rods in skin lesions and internal organs |
| Infectivity | Low | High |
| Immune response | Delayed hypersensitivity reactivity to lepromin | Nonreactivity to lepromin |
| Immunoglobulin levels | Normal | Hypergammaglobulinemia |
| Erythema nodosum | Absent | Usually present |
Patients with lepromatous leprosy (multibacillary Hansen disease) have a strong antibody response but a specific defect in the cellular response to M. leprae antigens. Thus an abundance of bacteria are typically observed in dermal macrophages and the Schwann cells of the peripheral nerves. As would be expected, this is the most infectious form of leprosy.
Epidemiology
Leprosy was first described in 600 BC and was recognized in the ancient civilizations of China, Egypt, and India. The global prevalence of leprosy has fallen dramatically with the widespread use of effective therapy. More than 5 million cases were documented in 1985 and fewer than 300,000 cases 20 years later. Currently, 90% of the cases are in Brazil, Madagascar, Mozambique, Tanzania, and Nepal. In the United States, leprosy is uncommon, with approximately 100 cases reported annually. Most cases occur in California and Hawaii and primarily in immigrants from Mexico, Asia, Africa, and the Pacific Islands. Interestingly, leprosy is endemic in armadillos found in Texas and Louisiana, producing a disease similar to the highly infectious lepromatous form of leprosy in humans. Thus these armadillos represent a potential endemic focus in this country.
Leprosy is spread by person-to-person contact. Although the most important route of infection is unknown, it is believed that M. leprae is spread either through the inhalation of infectious aerosols or through skin contact with respiratory secretions and wound exudates. Numerous M. leprae are found in the nasal secretions of patients with lepromatous leprosy.
M. leprae cannot grow in cell-free cultures. Thus laboratory confirmation of leprosy requires histopathologic findings consistent with the clinical disease and either skin test reactivity to lepromin in tuberculoid leprosy or observation of acid-fast bacteria in the lesions of patients with lepromatous leprosy.
Clinical Diseases
Leprosy is a chronic infection that affects the skin and peripheral nerves. The spectrum of tissue involvement is influenced by the patient’s immune status, as noted earlier (see Table 25-3). The tuberculoid form (Figure 25-6) is milder and is characterized by hypopigmented skin macules. The lepromatous form (Figure 25-7) is associated with disfiguring skin lesions, nodules, plaques, thickened dermis, and involvement of the nasal mucosa.
Mycobacterium avium Complex (Box 25-3)
The classification of mycobacteria in the M. avium complex has been defined recently by genomic-based studies. Two species, M. avium and M. intracellulare, and four subspecies are recognized currently (Table 25-4). Most reports in the literature refer to M. avium or M. avium complex as a cause of human disease. However, it appears that the strains responsible for avian disease (M. avium subsp. avium) are distinct from the strains responsible for most human disease (M. avium subsp. hominissuis). M. avium subsp. silvaticum has not been implicated in human disease, and a large body of literature has debated the role of M. avium subsp. paratuberculosis, the etiologic agent of chronic granulomatous enteritis (Johne disease) in ruminants, as a cause of chronic granulomatous enteritis in humans (Crohn disease). These taxonomic differences are important for understanding the epidemiology and pathogenesis of the M. avium complex strains responsible for human disease. However, for the purpose of this text, I will only use the terms M. avium (M. avium subsp. hominissuis) and M. avium complex (M. avium and M. intracellulare).
Box 25-3 Summary
Mycobacterium avium Complex
Biology, Virulence, and Disease
Epidemiology
Worldwide distribution, but disease is seen most commonly in countries where tuberculosis is less common
Acquired primarily through ingestion of contaminated water or food; inhalation of infectious aerosols is believed to play a minor role in transmission
Patients at greatest risk for disease are those who are immunocompromised (particularly patients with AIDS) and those with long-standing pulmonary disease
Table 25-4 Mycobacterium avium Complex
| Species | Disease |
|---|---|
| M. avium subsp. avium | Avian tuberculosis |
| M. avium subsp. hominissuis | Disease in humans and pigs; disseminated disease in HIV-infected patients; cervical lymphadenitis in children; chronic pulmonary disease in adolescents with cystic fibrosis and older adults with underlying pulmonary disease |
| M. avium subsp. silvaticum | Disease in wood pigeons |
| M. avium subsp. paratuberculosis | Chronic granulomatous enteric disease in ruminants (Johne disease) and possibly in humans (Crohn disease) |
| M. intracellulare | Pulmonary disease in immunocompetent patients |
Both species in the M. avium complex (MAC, a term commonly used today) produce disease in immunocompetent patients, whereas disease in HIV-infected patients is primarily caused by M. avium. Before the HIV epidemic, recovery of the organisms in clinical specimens typically represented transient colonization or, less commonly, chronic pulmonary disease. Pulmonary disease in immunocompetent patients presents in one of three forms. Most commonly, disease is seen in middle-age or older men with a history of smoking and underlying pulmonary disease. These patients typically have a slowly evolving cavitary disease that resembles tuberculosis on chest radiography. The second form of MAC infection is observed in elderly, female nonsmokers. These patients have lingular or middle lobe infiltrates with a patchy, nodular appearance on radiography and associated bronchiectasis (chronically dilated bronchi). This form of disease is indolent and has been associated with significant morbidity and mortality. It has been postulated that this disease is seen primarily in fastidious elderly women who chronically suppress their cough reflex, leading to nonspecific inflammatory changes in the lungs and predisposing them to superinfection with MAC. This specific disease has been called Lady Windermere syndrome, the name of the principle character in an Oscar Wilde play. The third form of MAC disease is formation of a solitary pulmonary nodule. M. avium complex is the most common mycobacterial species that causes solitary the pulmonary nodules.
A new spectrum of disease developed in patients with acquired immunodeficiency syndrome (AIDS), making infection with M. avium complex the most common mycobacterial disease in these patients in the United States. In contrast to disease in other groups of patients, MAC infection in patients with AIDS is typically disseminated, with virtually no organ spared (Clinical Case 25-2). The magnitude of these infections is remarkable; the tissues of some patients are literally filled with the mycobacteria (Figure 25-8), and there are hundreds to thousands of bacteria per milliliter of blood. Overwhelming disseminated infections with M. avium are particularly common in patients who are in the terminal stages of their immune disorder, when their CD4 T-lymphocyte counts fall to less than 10 cells/mm3. Fortunately, with more effective antiretroviral therapy and the routine use of prophylactic antibiotics, M. avium disease infections in HIV-infected patients have become much less common. Although some patients with AIDS develop M. avium disease after pulmonary exposure (e.g., infectious aerosols of contaminated water), most infections are believed to develop after ingestion of the bacteria. Person-to-person transmission has not been demonstrated. After exposure to the mycobacteria, replication is initiated in localized lymph nodes followed by systemic spread. The clinical manifestations of disease are not observed until the mass of replicating bacteria impairs normal organ function.
Clinical Case 25-2
Mycobacterium avium Infections in an AIDS Patient
Woods and Goldsmith (Chest 95:1355–1357, 1989) described a patient with advanced AIDS who died of disseminated M. avium infection. The patient was a 27-year-old man who initially presented in October 1985 with a 2-week history of progressive dyspnea and a nonproductive cough. Pneumocystis was detected in a bronchoalveolar lavage, and serology confirmed the patient had an HIV infection. The patient was successfully treated with trimethoprim-sulfamethoxazole and discharged. The patient remained stable until May 1987, when he presented with persistent fever and dyspnea. Over the next week, he developed severe substernal chest pain and a pericardial friction rub. Echocardiogram revealed a small effusion. The patient left the hospital against medical advice but returned 1 week later with a persistent cough, fever, and pain in the chest and left arm. A diagnostic pericardiocentesis was performed, and 220 ml of fluid was aspirated. Tuberculous pericarditis was suspected, and appropriate antimycobacterial therapy was initiated. However, over the next 3 weeks, the patient developed progressive cardiac failure and died. M. avium was recovered from the pericardial fluid, as well as autopsy cultures of the pericardium, spleen, liver, adrenal glands, kidneys, small intestine, lymph nodes, and pituitary gland. Although M. avium pericarditis was unusual, the extensive dissemination of the mycobacteria in patients with advanced AIDS was common before azithromycin prophylaxis became widely used.
Other Slow-Growing Mycobacteria
Many other slow-growing mycobacteria can cause human disease, and new species continue to be reported as better diagnostic test methods are developed. The spectrum of diseases produced by these mycobacteria also continues to expand, in large part because diseases such as AIDS, malignancies, and organ transplantation with concomitant use of immunosuppressive drugs have created a population of patients who are highly susceptible to organisms with relatively low virulence potential. Some mycobacteria produce disease identical to pulmonary tuberculosis (e.g., Mycobacterium bovis, M. kansasii), other species commonly cause infections localized to lymphatic tissue (Mycobacterium scrofulaceum), and others that grow optimally at cool temperatures primarily produce cutaneous infections (Mycobacterium ulcerans, M. marinum, Mycobacterium haemophilum). However, disseminated disease can be observed in patients with AIDS who are infected with these same species, as well as with relatively uncommon mycobacteria (e.g., Mycobacterium genavense, Mycobacterium simiae).
Most of these mycobacteria have been isolated in water and soil and occasionally from infected animals (e.g., M. bovis causes bovine tuberculosis). Often the isolation of these mycobacteria in clinical specimens simply represents transient colonization with organisms that the patient ingested. With the exception of M. bovis and other mycobacteria closely related to M. tuberculosis, person-to-person spread of these mycobacteria does not occur.
Rapidly Growing Mycobacteria
As discussed previously, NTM can be subdivided into slow-growing species and rapidly growing species (growth in less than 7 days). This distinction is important because the rapidly growing species have a relatively low virulence potential, stain irregularly with traditional mycobacterial stains, and are more susceptible to “conventional” antibacterial antibiotics than to drugs used to treat other mycobacterial infections. The most common species associated with disease are M. fortuitum, M. chelonae, M. abscessus, and M. mucogenicum.
The rapidly growing mycobacteria rarely cause disseminated infections. Rather, they are most commonly associated with disease occurring after bacteria are introduced into the deep subcutaneous tissues by trauma or iatrogenic infections (e.g., infections associated with an intravenous catheter, contaminated wound dressing, prosthetic device such as a heart valve, peritoneal dialysis, or bronchoscopy). Unfortunately, the incidence of infections with these organisms is increasing as more invasive procedures are performed in hospitalized patients and advanced medical care lengthens the life expectancy of immunocompromised patients. Opportunistic infections in immunocompetent patients are becoming commonplace (Clinical Case 25-3).
Clinical Case 25-3
Mycobacterial Infections Associated with Nail Salons
In September 2000 (Winthrop KL, et al: N Engl J Med 346:1366–1371, 2002) a physician reported to the California Department of Health four female patients who developed lower extremity furunculosis. Each patient presented with small erythematous papules that became large, tender, fluctuant, violaceous boils over several weeks. Bacterial cultures of the lesions were negative, and the patients failed empiric antibacterial therapy. All of the patients had visited the same nail salon before the furuncles developed. As a result of the investigation of the nail salon, a total of 110 patients with furunculosis were identified. Mycobacterium fortuitum was cultured from the lesions from 32 patients, as well as from the footbaths used by the patients before their pedicures. Shaving the legs was identified as a risk factor for disease. Similar outbreaks have been reported in the literature, which illustrates the risks associated with contamination of waters with rapidly growing mycobacteria; the difficulties of confirming these infections by routine bacterial cultures, which are typically incubated for only 1 to 2 days; and the need for effective antibiotic therapy.
Laboratory Diagnosis
The various laboratory tests used in the diagnosis of infections caused by mycobacteria are listed in Box 25-4.
Immunodiagnosis
The traditional test to assess the patient’s response to exposure to M. tuberculosis is the tuberculin skin test. Reactivity to an intradermal injection of mycobacterial antigens can differentiate between infected and noninfected people, with a positive PPD reaction usually developing 3 to 4 weeks after exposure to M. tuberculosis. The only evidence of infection with mycobacteria in most patients is a lifelong positive skin test reaction and radiographic evidence of calcification of granulomas in the lungs or other organs.
The methods of antigen preparation have been changed many times since the tests were first developed. The currently recommended tuberculin antigen is a PPD from the mycobacterial cell wall. In this test, a specific amount of the antigen (5 tuberculin units of PPD) is inoculated into the intradermal layer of the patient’s skin. Skin test reactivity (defined by the diameter of the area of induration) is measured 48 hours later. Patients infected with M. tuberculosis may not show a response to the tuberculin skin test if they are anergic (nonreactive to antigens; particularly true of HIV-infected patients); thus control antigens should always be used with tuberculin tests. Additionally, individuals from countries where vaccination with attenuated M. bovis (bacille Calmette-Guérin [BCG]) is widespread (refer to later discussion, Immunoprophylaxis) will have a positive skin test reaction.
In recent years, in vitro IFN-γ release assays have been introduced as an alternative to the PPD skin test. The tests use immunoassays to measure IFN-γ produced by sensitized T cells stimulated by M. tuberculosis antigens. If an individual was previously infected with M. tuberculosis, exposure of sensitized T cells present in whole blood to M. tuberculosis–specific antigens results in IFN-γ production. The initial assays that used PPD as the stimulating antigen have been replaced with second-generation assays that use more specific antigens (i.e., early secreted antigenic target-6 [ESAT-6], culture filtrate protein-10 [CFP-10]) and can be used to discriminate between infections with M. tuberculosis and BCG vaccination. Although the tests are sensitive and highly specific, the technical complexity of the assays currently limits their use.
Reactivity to lepromin, which is prepared from inactivated M. leprae, is valuable for confirming the clinical diagnosis of tuberculoid leprosy. Papular induration develops 3 to 4 days after the intradermal injection of the antigen. This test is not useful for identifying patients with lepromatous leprosy because such patients are anergic to the antigen.
Microscopy
The microscopic detection of acid-fast bacteria in clinical specimens is the most rapid way to confirm mycobacterial disease. The clinical specimen is stained with carbolfuchsin (Ziehl-Neelsen or Kinyoun methods) or fluorescent auramine-rhodamine dyes (Truant fluorochrome method), decolorized with an acid-alcohol solution, and then counterstained. The specimens are examined with a light microscope or, if fluorescent dyes are used, a fluorescent microscope (Figure 25-9). The fluorochrome method is the most sensitive method because the specimen can be scanned rapidly under low magnification for fluorescent areas, and then the presence of acid-fast bacteria can be confirmed with higher magnification.


Figure 25-9 Acid-fast stains of Mycobacterium tuberculosis. A, Stained with carbolfuchsin using the Kinyoun method. B, Stained with the fluorescent dyes auramine and rhodamine using the Truant fluorochrome method.
In approximately half of all culture-positive specimens, acid-fast bacteria are detected by microscopy. The sensitivity of this test is high for (1) respiratory specimens (particularly from patients with radiographic evidence of cavitation) and (2) specimens for which many mycobacteria are isolated in culture. Thus a positive acid-fast stain reaction corresponds to higher infectivity. The specificity of the test is greater than 95% when it is performed carefully.
Nucleic Acid–Based Tests
Although microscopy provides useful information regarding the presence of mycobacterial disease, it cannot identify the particular mycobacterial species involved. For this reason, techniques have been developed to detect specific mycobacterial nucleic acid sequences present in clinical specimens. Because only a few bacteria may be present, commercial companies have developed a variety of nucleic acid amplification techniques (e.g., polymerase chain reaction [PCR]). The commercial assays currently used are specific for M. tuberculosis but are relatively insensitive. In addition, the assays cannot be used to identify nontuberculosis mycobacteria. A gene encoding a secretory protein, secA gene, has been demonstrated to be a useful target for identifying all species of mycobacteria directly in clinical specimens. The gene can be amplified by PCR, and then the species-specific portion of the gene can be sequenced to determine the identity of the isolate. The test is highly sensitive with acid-fast smear-positive specimens and specific, but it is relatively insensitive in smear-negative specimens. A commercial, 1-hour PCR amplification assay was introduced in 2010; it can detect M. tuberculosis in clinical specimens and also determine susceptibility to rifampin, a surrogate marker for multidrug-resistant strains. Although the initial test is expensive, additional commercial products could allow rapid, routine testing in countries with a high incidence of disease and where microscopy and culture are impractical.
Culture
Mycobacteria that cause pulmonary disease, particularly in patients with evidence of cavitation, are abundant in the respiratory secretions (e.g., 108 bacilli per milliliter or more). Recovery of the organisms is virtually assured in patients from whom early morning respiratory specimens are collected for 3 consecutive days; however, it is more difficult to isolate M. tuberculosis and NTM species from other sites in patients with disseminated disease (e.g., genitourinary tract, tissues, cerebrospinal fluid). In such cases, additional specimens must be collected for cultures, and a large volume of fluid or tissue must be processed.
The in vitro growth of mycobacteria is complicated by the fact that most isolates grow slowly and can be obscured by the rapidly growing bacteria that normally colonize people. Thus specimens such as sputum are initially treated with a decontaminating reagent (e.g., 2% sodium hydroxide) to eliminate organisms that could confound results. Mycobacteria can tolerate brief alkali treatment that kills the rapidly growing bacteria and permits the selective isolation of mycobacteria. Extended decontamination of the specimen kills mycobacteria, so the procedure is not performed when normally sterile specimens are being tested or when few mycobacteria are expected.
Formerly, when specimens were inoculated onto egg-based (e.g., Löwenstein-Jensen) and agar-based (e.g., Middlebrook) media, it generally took 4 to 8 weeks for M. tuberculosis, M. avium complex, and other important slow-growing mycobacteria to be detected. However, this time has been shortened through the use of specially formulated broth cultures that support the rapid growth of most mycobacteria. Thus the average time to grow mycobacteria has been decreased from 10 to 21 days.
The ability of M. tuberculosis to grow rapidly in broth cultures has been used for performing rapid susceptibility tests. The technique, MODS or microscopic observation drug susceptibility assay, uses an inverted light microscope to examine 24-well plates inoculated with Middlebrook broth and decontaminated sputum. M. tuberculosis growth can be detected as tangles or cords of growth in the broth, generally after 1 week of incubation. Incorporation of antimycobacterial drugs in the broth enables rapid, direct susceptibility testing with clinical specimens. This technique is widely available in laboratories servicing developing countries where drug-resistant strains of M. tuberculosis are widespread.
Some mycobacterial species (e.g., M. marinum, M. haemophilum, M. malmoense) require a lower incubation temperature than that used for most cultures (30° C versus 37° C). In addition, M. haemophilum requires supplementation of media with hemin or ferric ammonium citrate for growth. Because infections with these organisms characteristically involve the skin, laboratories should culture superficial specimens (e.g., skin biopsies and lesions) at both 30° C and 37° C and on at least one medium supplemented with hemin.
Identification
Growth properties and colonial morphology can be used for the preliminary identification of the most common species of mycobacteria. The definitive identification of mycobacteria can made using a variety of techniques. Biochemical tests were the standard method for identifying mycobacteria; however, the results are not available for at least 3 weeks or more, and many species cannot be differentiated by this approach. Species-specific molecular probes are the most useful means of identifying commonly isolated mycobacteria (e.g., M. tuberculosis, M. avium, M. kansasii), and, because many organisms are present in the culture at the time of initial detection, it is not necessary to amplify the target genomic sequence. The commercially prepared probe identification systems currently used are rapid (test time, 2 hours), sensitive, and specific. Mycobacterial species for which probes are not available can be identified by amplifying species-specific gene sequences (e.g., hypervariable regions of the 16S rRNA gene or secA gene), followed by sequence analysis to identify the species. This method is rapid (1 to 2 days), is not limited by the availability of specific probes, and is likely to replace the alternative identification methods.
Treatment, Prevention, and Control
Treatment
The treatment and prophylaxis of mycobacterial infections, unlike those for most other bacterial infections, are complex and controversial. Slow-growing mycobacteria are resistant to most antibiotics used to treat other bacterial infections. In general, patients must take multiple antibiotics for an extended period (e.g., a minimum of 6 to 9 months) or else antibiotic-resistant strains will develop. In 1990, the first outbreaks of multidrug-resistant M. tuberculosis (MDR TB; resistant to at least isoniazid and rifampin) were observed in patients with AIDS and in homeless persons in New York City and Miami. Although there has been a reduction in the United States of infections with these resistant strains, they are increasing dramatically in prevalence in developing countries. In addition, new strains of resistant M. tuberculosis, called extensively drug-resistant (XDR) TB, have emerged in most regions of the world. These strains, defined as MDR TB that are resistant to fluoroquinolones and at least one of the second-line drugs (e.g., kanamycin, amikacin, capreomycin), are potentially untreatable.
The number of treatment regimens that have been developed for drug-susceptible and drug-resistant tuberculosis is too complex to review here comprehensively (refer to the Centers for Disease Control and Prevention [CDC] website, www.cdc.gov/tb/). Most treatment regimens begin with 2 months of isoniazid (isonicotinyl-hydrazine [INH]), ethambutol, pyrazinamide, and rifampin, followed by 4 to 6 months of INH and rifampin or alternative combination drugs. Modifications to this treatment scheme are dictated by the drug susceptibility of the isolate and the patient population.
In the last decade, treatment of leprosy has successfully reduced the overall incidence of disease. The treatment regimens advanced by the WHO (http://WHO.int/lep) have distinguished between patients with the tuberculoid (paucibacillary) form and the lepromatous (multibacillary) form. The paucibacillary form should be treated with rifampicin and dapsone for a minimum of 6 months, whereas the multibacillary form should have clofazimine added to the regimen, and treatment should be extended to 12 months. It should be noted that many investigators believe much longer therapy is required for optimum management of patients. Single-drug treatment should not be used for either form.
M. avium complex and many other slow-growing mycobacteria are resistant to common antimycobacterial agents. One regimen recommended currently for MAC infections is clarithromycin or azithromycin, combined with ethambutol and rifampin. The American Thoracic Society has recommended that M. kansasii infections be treated with INH, rifampin, and ethambutol. The duration of treatment and final selection of drugs for these species and other slow-growing mycobacteria are determined by (1) the response to therapy and (2) interactions among these drugs and other drugs the patient is receiving (e.g., toxic and pharmacokinetic interactions of these drugs with protease inhibitors used to treat HIV infection). Refer to the publication by Griffith and associates cited in the Bibliography for additional information about treating NTM infections.
Unlike the slow-growing mycobacteria, the rapidly growing species are resistant to most commonly used antimycobacterial agents but are susceptible to antibiotics such as clarithromycin, imipenem, amikacin, cefoxitin, and the sulfonamides. The specific activity of these agents must be determined with in vitro tests. Because infections with these mycobacteria are generally confined to the skin or are associated with prosthetic devices, surgical debridement or removal of the prosthesis is also necessary.
Chemoprophylaxis
The American Thoracic Society and the CDC have examined a number of prophylactic regimens for use in patients (HIV positive and HIV negative) exposed to M. tuberculosis. The regimens that have been recommended include daily or twice weekly INH for 6 to 9 months, or daily rifampin for 4 months. Patients who have been exposed to drug-resistant M. tuberculosis should receive prophylaxis with pyrazinamide and either ethambutol or levofloxacin for 6 to 12 months. Because M. avium complex intracellular infections are common in patients with AIDS, chemoprophylaxis is recommended for patients whose CD4 T-cell counts fall to less than 50 cells/µl. Prophylaxis with clarithromycin or azithromycin is recommended. Combinations of these drugs with rifabutin have been used, but they are generally more toxic and no more effective than the single agent. Chemoprophylaxis is unnecessary for patients with other mycobacterial infections.
Immunoprophylaxis
Vaccination with attenuated M. bovis (BCG) is commonly used in countries where tuberculosis is endemic and is responsible for significant morbidity and mortality. This practice can lead to a significant reduction in the incidence of tuberculosis if BCG is administered to people when they are young (it is less effective in adults). Unfortunately, BCG immunization cannot be used in immunocompromised patients (e.g., those with HIV infection). Thus it is unlikely to be useful in countries with a high prevalence of HIV infections (e.g., Africa) or to control the spread of drug-resistant tuberculosis. An additional problem with BCG immunization is that positive skin test reactivity develops in all patients and may persist for a prolonged time. However, skin test reactivity is generally low, so a strongly reactive skin test (e.g., greater than 20 mm of induration) is generally significant. The second-generation IFN-γ release assays are not affected by BCG immunization, so they can be used for screening this population. BCG immunization is not widely used in the United States or in other countries where the incidence of tuberculosis is low.
A 35-year-old man with a history of intravenous drug use entered the local health clinic with complaints of a dry persistent cough, fever, malaise, and anorexia. Over the preceding 4 weeks, he had lost 15 pounds and experienced chills and sweats. A chest radiograph revealed patchy infiltrates throughout the lung fields. Because the patient had a nonproductive cough, sputum was induced and submitted for bacterial, fungal, and mycobacterial cultures, as well as examination for Pneumocystis organisms. Blood cultures and serologic tests for HIV infection were performed. The patient was found to be HIV positive. The results of all cultures were negative after 2 days of incubation; however, cultures were positive for M. tuberculosis after an additional week of incubation.
1. What is unique about the cell wall of mycobacteria, and what biologic effects can be attributed to the cell wall structure?
2. Why is M. tuberculosis more virulent in patients with HIV infection than in non–HIV-infected patients?
3. What are the two clinical presentations of M. leprae infections? How do the diagnostic tests differ for these two presentations?
4. Why do mycobacterial infections have to be treated with multiple drugs for 6 months or more?
1. Mycobacteria are unique in that their cell wall has long chain (i.e., 70 to 90 carbons) mycolic acids. The unique lipid-rich cell wall renders the organisms acid-fast and resistant to detergents, common antibacterial antibiotics, and many disinfection procedures.
2. In a normal host, replication of mycobacteria stimulates helper (CD4+) and cytotoxic (CD8+) T cells. T cells release IFN-γ and other cytokines that activate macrophage, which can engulf and destroy the mycobacteria. Because HIV-positive patients have a depression of CD4+ cells, immune clearance of mycobacteria is impeded. Thus these patients have a more rapid progression of disease compared with immunocompetent patients.
3. The spectrum of clinical disease caused by M. leprae ranges from tuberculoid leprosy to lepromatous leprosy. Tuberculoid leprosy is a milder form characterized by hypopigmented skin macules, relatively few bacilli observed in the tissue, and a strong cellular immune reaction (positive skin test). The lepromatous form of leprosy is associated with disfiguring skin lesions, nodules, plaques, thickened dermis, and involvement of the nasal mucosa. Patients with the lepromatous form have a strong antibody response to the bacilli but a defect in cellular immunity. Because cellular immunity is responsible for the clearance of the bacilli, this defect is associated with an abundance of bacilli observed in the infected tissues.
4. Mycobacteria are relatively slow multiplying organisms. Thus prolonged therapy is required to eliminate the bacteria. Approximately 1 in every 100,000 to 1,000,000 bacteria will develop resistance to an antibiotic used for treatment. Large numbers of bacilli are typically present in an infection, so if a single antibiotic is used for treatment, resistant bacilli will be selected rapidly. Therefore multiple antibiotics prescribed over many months are commonly used to treat an infected patient.
Appelberg R. Pathogenesis of Mycobacterium avium infection. Immunol Res. 2006;35:179–190.
Bottasso O, et al. The immuno-endocrine component in the pathogenesis of tuberculosis. Scan J Immunol. 2007;66:166–175.
Centers for Disease Control and Prevention. Guidelines for preventing opportunistic infections among HIV-infected persons—2002 recommendations of the U.S. Public Health Service and the Infectious Diseases Society of America. MMWR. 2002;51(RR-8):1–53.
De Groote M, Huitt G. Infections due to rapidly growing mycobacteria. Clin Infect Dis. 2006;42:1756–1763.
Drobniewski F, et al. Antimicrobial susceptibility testing of Mycobacterium tuberculosis. Clin Microbiol Infect. 2007;13:1144–1156.
Flynn JL, Chan J. Immune evasion by Mycobacterium tuberculosis: living with the enemy. Curr Opin Immunol. 2003;15:450–455.
Griffith D, et al. An official ATS/IDSA statement: diagnosis, treatment, and prevention of nontuberculous mycobacterial diseases. Am J Respir Crit Care Med. 2007;175:367–416.
Jacobson K, et al. Mycobacterium kansasii infections in patients with cancer. Clin Infect Dis. 2000;30:965–969.
Karakousis PC, Bishai WR, Dorman SE. Microreview: Mycobacterium tuberculosis cell envelope lipids and the host immune response. Cell Microbiol. 2004;6:105–116.
Mazurek G, et al. Updated guidelines for using interferon gamma release assays to detect Mycobacterium tuberculosis infection—United States, 2010. MMWR Recomm Rep. 2010;59(RR-5):1–24.
Shah MK, et al. Mycobacterium haemophilum in immunocompromised patients. Clin Infect Dis. 2001;33:330–337.
Smith I. Mycobacterium tuberculosis pathogenesis and molecular determinants of virulence. Clin Microbiol Rev. 2003;16:463–496.
Turenne C, et al. Mycobacterium avium in the postgenomic era. Clin Microbiol Rev. 2007;20:205–229.
Ulrichs T, Kaufmann S. New insights into the function of granulomas in human tuberculosis. J Pathol. 2006;208:261–269.
Wells C, et al. HIV infection and multidrug-resistant tuberculosis—the perfect storm. J Infect Dis. 2007;196:S86–S107.
Yew W, Leung C. Update in tuberculosis 2006. Am J Respir Crit Care Med. 2007;175:541–546.